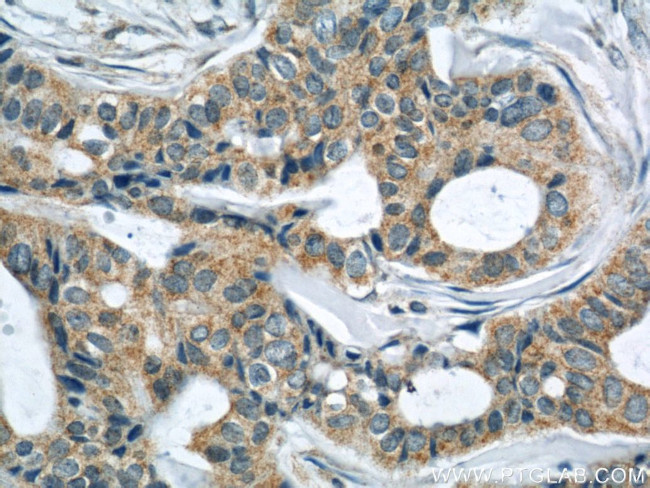
LATH Antibody in Immunohistochemistry (Paraffin) (IHC (P))
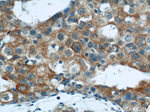
LATH Antibody in Immunohistochemistry (Paraffin) (IHC (P))

Search
Proteintech
LATH Polyclonal Antibody
{{$productOrderCtrl.translations['antibody.pdp.commerceCard.promotion.promotions']}}
{{$productOrderCtrl.translations['antibody.pdp.commerceCard.promotion.viewpromo']}}
{{$productOrderCtrl.translations['antibody.pdp.commerceCard.promotion.promocode']}}: {{promo.promoCode}} {{promo.promoTitle}} {{promo.promoDescription}}. {{$productOrderCtrl.translations['antibody.pdp.commerceCard.promotion.learnmore']}}
产品信息
19763-1-AP
种属反应
宿主/亚型
分类
类型
抗原
偶联物
形式
浓度
规格
纯化类型
保存液
内含物
保存条件
运输条件
靶标信息
The PLUNC family of proteins are encoded by genes which map to chromosome 20 and are thought to play a potential role in the innate immune response in regions of the mouth, nose and lungs. As a member of the PLUNC family, BASE (breast cancer and salivary gland-expressed protein) is a 179 amino acid secreted protein that is named for its expression pattern. Due to its 63% sequence similarity with the related protein, Latherin, it is suggested that BASE is the major protein in sweat secretions and has important surfactant properties that lower surface tension. The expression pattern of BASE in many breast cancer cell lines suggests that it may be an easily accessible diagnostic breast cancer marker. Due to the fact that the gene encoding BASE is highly estrogen-repressed, expression of the gene is most likely dependent on HNF-3alpha and estrogen-mediated repression requiring ERalpha.
仅用于科研。不用于诊断过程。未经明确授权不得转售。